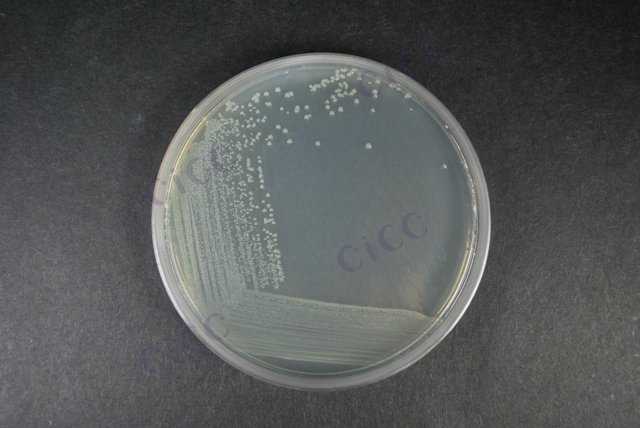
产气肠杆菌 Enterobacter aerogenes CICC 10293 Enterobacter aerogenes

产气肠杆菌 Enterobacter aerogenes CICC 10293 Enterobacter aerogenes
-
产气肠杆菌 Enterobacter aerogenes CICC 10418 Enterobacter aerogenes
CICC 10418 | 见证书
-
产气克雷伯菌 Enterobacter aerogenes ATCC 35028 Culti-Loop Enterobacter aerogenes ATCC® 35028™
R4607081 | 5支/包
-
产气克雷伯菌 Enterobacter aerogenes ATCC 35029 Culti-Loop Enterobacter aerogenes ATCC® 35029™
R4607082 | 5支/包
-
Enterobacter aerogenes
CICC 22007 | 见证书
-
Enterobacter aerogenes
CICC 23062 | 见证书
-
分支酸 来源于产气肠杆菌 Chorismic acid, from Enterobacter aerogenes
R152070-5mg | 5mg
-
产气克雷伯菌 Klebsiella aerogenes ATCC 49701 Culti-Loop Enterobacter aerogenes ATCC 49701
R4601941 | 5支/包

说明书下载: 菌种说明书 打管说明书
您正在浏览的产品:产气肠杆菌 Enterobacter aerogenes CICC 10293
手机版:产气肠杆菌 Enterobacter aerogenes CICC 10293
本公司销售的所有产品仅供实验科研使用,不用于人体及临床诊断。
2. 分子生物学法:PCR技术检测特异性DNA序列,需结合测序验证[2]。
定量限:MPN法适用于低菌量样本,平板计数法要求≥10 CFU/g[4]。
2. 阴性对照:无菌生理盐水或已知阴性样本平行检测[2][4]。
2. 选择性培养:36±1℃孵育18-24小时,观察菌落形态与产气现象。
3. 生化鉴定:完成氧化酶、IMViC、鸟氨酸脱羧酶等系列试验[2][4]。
2. 药敏试验需遵循CLSIM100-S20标准,重点关注β-内酰胺类耐药性[2]。
以上信息仅供参考,请以相应标准的原文为准!